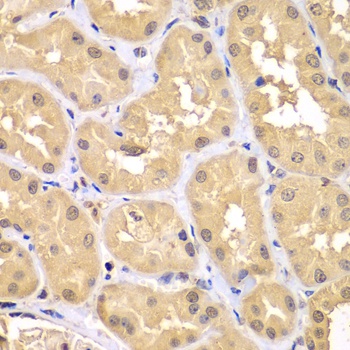
Product Image

Description
TRIM69 Antibody (CAB5910)
The TRIM69 Antibody (CAB5910) is a high-quality antibody developed for reliable detection and analysis of target proteins. This antibody, produced in rabbits, is highly specific to human samples and has been validated for use in Western blot applications. By binding to the TRIM69 protein, this antibody allows for accurate detection and analysis in a range of cell types, making it essential for studies in molecular biology and cancer research.TRIM69, a member of the tripartite motif-containing (TRIM) protein family, has been implicated in immune response regulation, viral infection defense, and cell proliferation control.
This antibody is validated for use in - applications and has demonstrated reactivity against - samples.
| Product Name: | TRIM69 Antibody |
| SKU: | CAB5910 |
| Size: | 20μL, 100μL |
| Sequence: | MEEE LAIQ QGQL ETTL KELQ TLRN MQKE AIAA HKEN KLHL QQHV SMEF LKLH QFLH SKEK DILT ELRE EGKA LNEE MELN LSQL QEQC LLAK DMLV SIQA KTEQ QNSF DFLK DITT LLHS LEQG MKVL ATRE LISR KLNL GQYK GPIQ YMVW REMQ DTLC PGLS PLTL DPKT AHPN LVLS KSQT SVWH GDIK KIMP DDPE RFDS SVAV LGSR GFTS GKWY WEVE VAKK TKWT VGVV RESI IRKG SCPL TPEQ GFWL LRLR NQTD LKAL DLPS FSLT LTNN LDKV GIYL DYEG GQLS FYNA KTMT HIYT FSNT FMEK LYPY FCPC LNDG GENK EPLH ILHP Q |
| Tested Applications: | - |
| Recommended Dilution: |